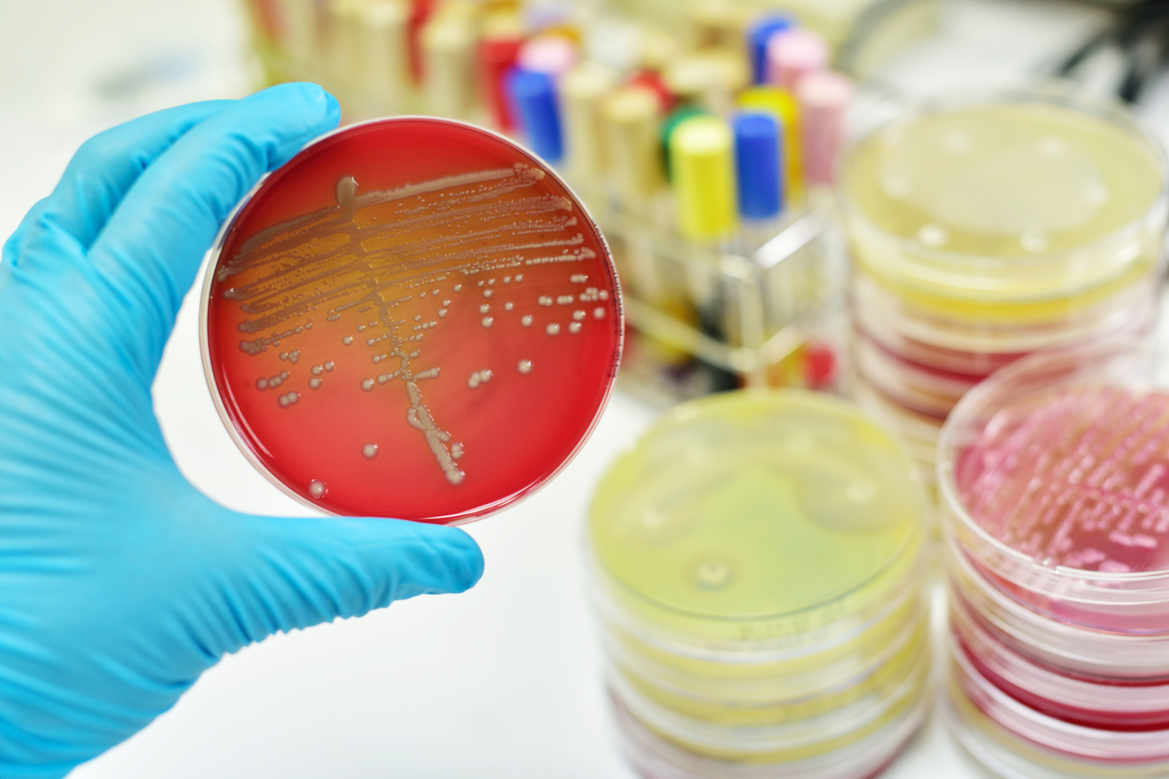

Du nouveau sur le staphylocoque doré
Dernière mise à jour 25/04/16 | Audio
Loading the player ...
@iStock/jarun011
Quentin Bohlen s'intéresse une bactérie bien connue dans le milieu hospitalier: le staphylocoque doré.
Ce germe provoque différents types d’infections nosocomiales dont l'issue peut-être fatale. Une équipe de recherche a séquencé l’entier du génome de la bactérie afin de mieux comprendre comment elle se diffuse.
On en parle avec Dominique Blanc, responsable du Laboratoire d’épidémiologie au Service de médecine préventive hospitalière au CHUV.
Une émission CQFD - RTS La Première
Articles sur le meme sujet

Echinococcus: une maladie silencieuse qui peut être grave
Les renards sont les principaux hôtes de ce parasite, aussi appelé «ténia du renard», qui peut se transmettre aux humains et causer d’importants dégâts au foie.

Un voyageur averti en vaut deux!
Afin d’éviter que vos vacances de rêve ne tournent au cauchemar, prenez toutes les précautions nécessaires pour votre santé – vaccins, prévention de la malaria, etc. – en particulier si votre destination se trouve dans des contrées lointaines. Un spécialiste détaille les 10 questions principales à se poser avant le grand départ.

La malaria, cauchemar du voyageur
Maladie fréquente en Afrique, Asie et Amérique du Sud, la malaria (ou paludisme) est un fléau pour la population locale mais également pour les touristes. C’est en effet l’infection qui occasionne le plus de décès chez les voyageurs! Quelques pistes pour s’en prémunir.

